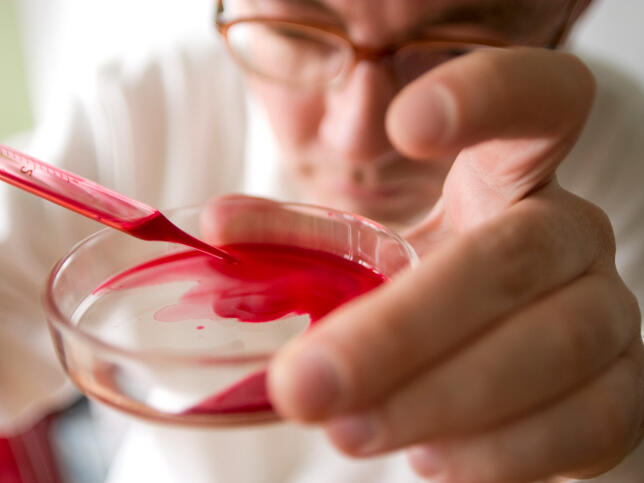

Сега, след като сте наясно по въпроса за различните видове кръв, можем да си поговорим по-подробно за основните нейни компоненти, за които стана дума накратко в предходния материал, а именно – червените и бели кръвни клетки и плазмата.
Червените кръвни клетки са частицата, която отговаря за транспорта на кислород из тялото и на въглероден диоксид навън от него. Те са изградени от един протеин, който се нарича хемоглобин – на червения му цвят се дължи и специфичното оцветяване на кръвта. В хемоглобина има големи количества желязо, за което кислородът буквално се закача и се доставя до нуждаещите се клетки.
Червените кръвни телца също така пренасят и около 14% от произведения въглероден диоксид от клетките обратно в дробовете за издишане. Останалите 86% се транспортират в кръвта под формата на бикарбонат.
Колкото до белите кръвни клетки, те са известни още като левкоцити и са част от имунитета ни, който ни предпазва/лекува от всякакви болести. Във всеки момент в 1 микролитър (0,001 мл) от нашата кръв има между 4 и 10 хиляди от тях. Ако случайно станат още повече, това обикновено означава, че тялото ни се опитва да се пребори с някаква инфекция.
Левкоцитите биват шест основни вида – неутрофили, еозинофили, базофили, лимфоцити, моноцити и магрофаги. Всеки вид играе различна роля в зависимост от естеството на щетата, която организмът ви се опитва да преодолее. Неутрофилите, например, убиват бактерии, като чисто и просто ги изяждат. Затова, когато страдаме от бактериална инфекция, нивото на неутрофили в кръвта ни е завишено. Това знание помага на съвременната медицина да установи с по-голяма точност каква е причината за нашето неразположение.
Последната част от кръвта е кръвната плазма. 90% от нея е гола вода, но има едни 8%, които са под формата на протеини като албумина, който е транспортно средство за молекули като калция и някои лекарства; някои антитела, които имат противовъзпалителни функции; и фибриноген и съсирващи фактори (важни за съсирването на кръвта). Останалите 2% от плазмата съдържат хормони като инсулина, електролити (калий, натрий), глюкоза и някои витамини.
В най-общи линии, това е. Важно е, също така, да не проливате излишна кръв, освен ако не е с благотворителни цели. А ако случайно се случи така, че се изцапате с безценната течност, накиснете пострадалата дреха за около 15 минути ьв топла вода с малко амоняк и прах за пране. След това изперете по стандартния начин. И много здраве на леля ви Мария с брадавиците!

Добави коментар